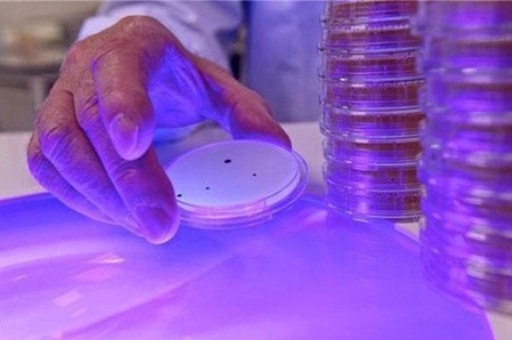
Учёные выявили новое полезное свойство солнечного света

Исследователи выяснили, что положительное воздействие дневного светила на человека не ограничивается только помощью в выработке витамина D.
Учёные из Медицинского центра Джорджтаунского университета (США) выявили новое полезное свойство солнечного света. Оказалось, что он влияет и на укрепление иммунной системы человека. Об этом специалисты сообщили в журнале Scientific Reports.
Для солнечного света характерен низкий уровень синей части спектра видимого излучения. Именно он заставляет быстрее двигаться Т-лимфоциты, которые принимают основное участие в работе иммунитета. В итоге кожа, на которую попадает солнечный свет, лучше защищается от болезнетворных микробов. Это подтверждает и эффективность использования кварцевых ламп синего света (рефлектора Минина).